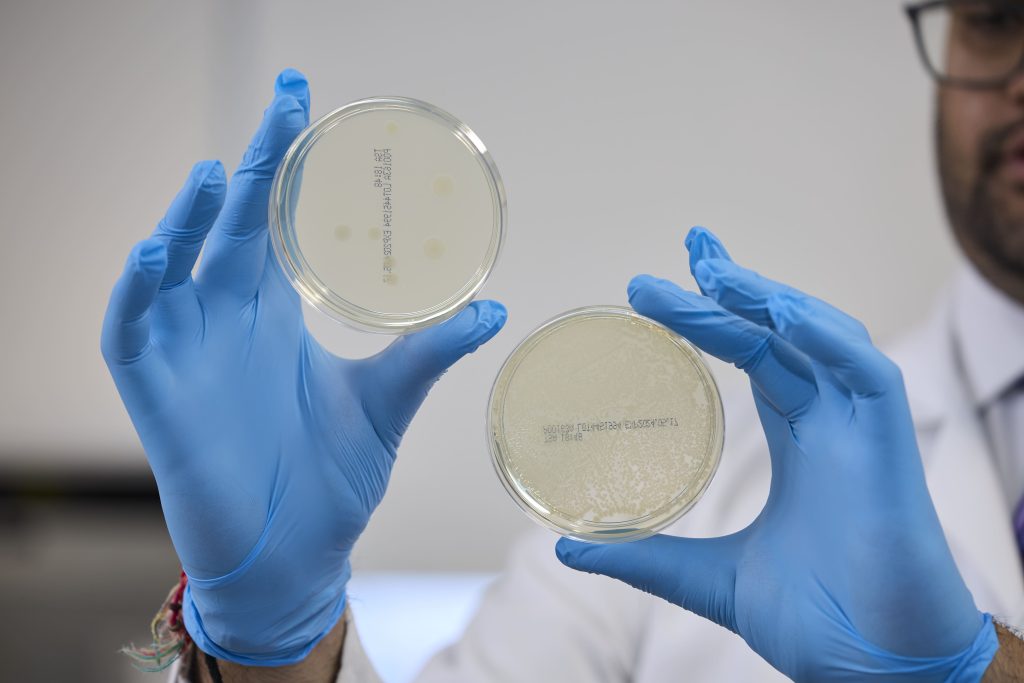

The Home of
Surface-Active Systems
Surface-Active Systems
Surface-Active Systems is a new category of high-performance and extremely safe biocompatible coating solutions designed to enhance implant performance, improve patient safety and evolve the therapeutic benefits and quality of life for patients worldwide.
Our innovative Surface-Active Systems comprises of both Surface-Active Therapeutics and Surface-Active Materials, to address the rising demands in infection prevention, thrombosis control and reduction in friction to advance device performance and longevity across a growing range of minimally invasive and implantable devices.

Surface-Active
Therapeutic
Long-lasting antithrombogenic and fibrin sheath protection

Surface-Active
Therapeutic
Powerful, persistent and full-spectrum antimicrobial action

Surface-Active
Material
Flexible and durable frictionless
enhancement
Product Pathway Partnership

Bespoke Materials
Our facilities include a custom designed production laboratory, enabling effective routine tasking as well as highly sophisticated operation by our team of skilled technicians and scientists.
On-site, we utilise a broad spectrum of high-tech equipment, from fully customised polymerisation rigs, to analytical resources, such as FT-IR and GPC. In addition, we work closely with established external laboratories to further enhance our range of analytical resources and provide the best in quality testing solutions.
We also house a vibrant and innovative Research and Development department, focused on delivering the next generation of cutting-edge biomaterials through both in-house projects and collaborative partnerships.
